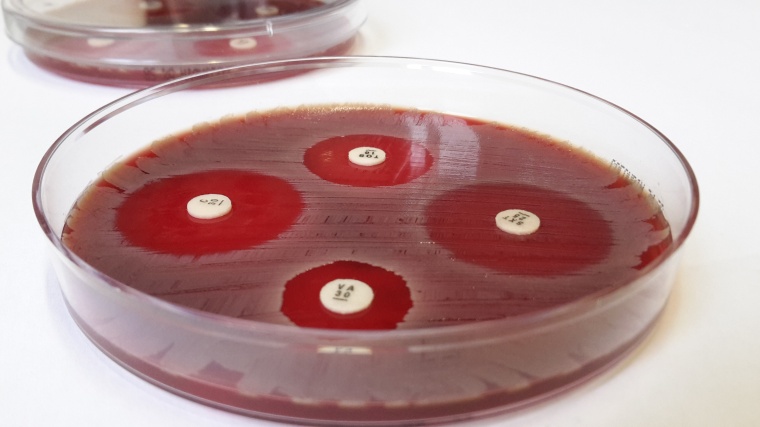
Der Plättchentest macht Antibiotika-Resistenzen sichtbar. Foto: Fabian...

Antibiotikaresistenzen im Fokus der Forschung
Die rasante Ausbreitung von Antibiotika-resistenten Bakterien hat weltweit die Infektionsforscher auf den Plan gerufen.
Welche Mechanismen schützen die Bakterien und mit welchen Methoden kann man sie erneut angreifbar machen? Bereits 2011 postulierten Wissenschaftler in einem Science-Artikel, dass Bakterien durch Sulfid (Schwefelwasserstoff) vor verschiedenen Antibiotika geschützt werden. Einen solchen „universellen“ Resistenzmechanismus konnte der DZIF-Wissenschaftler Fabian Grein nun jedoch mit einer neuen Technik widerlegen.
Mit seiner Arbeitsgruppe an der Universität Bonn untersuchte Fabian Grein den Einfluss von Sulfid auf die Empfindlichkeit von Staphylococcus aureus gegenüber den wichtigsten Antibiotikaklassen. „Zielstrukturen gegen Staphylokokken“ sind das Thema des Nachwuchsgruppenleiters im DZIF und so lag es auf der Hand, auch das „Sulfid-Postulat“ an Staphylokokken zu überprüfen, die zu den gefürchteten Krankenhauskeimen zählen. Welcher Mechanismus könnte dieser angenommenen Schutzfunktion von Sulfid zugrunde liegen? Und könnte man diesen gezielt angreifen und damit die Resistenz der Bakterien brechen?
Schützt Sulfid die Bakterien universell vor Antibiotika?
Um die Wirkung von Sulfid auf die Bakterien untersuchen zu können, mussten die Wissenschaftler zunächst einen modifizierten Agardiffusionstest entwickeln, der eine kontinuierliche Inkubation mit Sulfid ermöglicht. Nur so kann der schnellen Oxidation des Schwefelwasserstoffs entgegengewirkt werden. Mit diesem System wurden die Staphylokokken systematisch und vergleichend mit den wichtigsten Antibiotikaklassen konfrontiert.
„Wir konnten mit unserer Technik zeigen, dass Sulfid die Bakterien ausschließlich vor Aminoglykosiden schützt“, erklärt Fabian Grein. Aminoglykoside sind eine heterogene Gruppe von Antibiotika, die die Proteinbildung bei den Bakterien stören und so ihren Tod herbeiführen. Wichtige Vertreter sind Gentamicin, Streptomycin oder Kanamycin.
Bislang wurde angenommen, dass Sulfid den oxidativen Stress reduziert, der durch jede Antibiotikabehandlung entstehen soll. Dieses Postulat konnten die Forscher des DZIF-Forschungsbereichs „Krankenhauskeime und Antibiotika-resistente Bakterien“ nun widerlegen. „Aminoglykoside müssen als einzige Antibiotikaklasse die Bakterienmembran energieabhängig durchqueren, um mit ihrem Ziel in Kontakt zu kommen“, erklärt Fabian Grein. Mit seiner Gruppe konnte er zeigen, dass zugegebenes Sulfid die Zelle partiell vergiftet, so dass nicht mehr genügend Energie für die Aufnahme der Aminoglykosid-Antibiotika zur Verfügung steht. Die Zelle ist somit geschützt. Dieser Mechanismus ähnelt dem der sogenannten „Small Colony Variants“ (kurz: SCV). Diese S. aureus-Subpopulationen bilden sich besonders bei chronisch-persistierenden Infektionen. SCVs weisen aufgrund von Mutationen ein geringeres Membranpotential auf und sind durch die verringerte Aminoglykosid-Aufnahme resistent gegenüber dieser Antibiotikaklasse.
Überraschendes Ergebnis
Fabian Grein gibt zu, dass er selbst etwas überrascht war, das jahrelange Postulat der „universellen Schutzfunktion“ von Sulfid zu Fall gebracht zu haben. „Wir sehen außerdem, dass die Produktionsmengen von Sulfid zwischen verschiedenen Bakterienarten stark variieren und im Fall von Staphylococcus aureus für einen effektiven Schutz gegenüber Antibiotika zu gering sind.“
Grein und sein Team wollen nun weiter nach neuen Zielstrukturen gegen Staphylokokken suchen. „Es wäre natürlich schön gewesen, eine Substanz wie Sulfid als Schuldigen dingfest machen zu können und auf der Basis eine universelle Strategie gegen Antibiotikaresistenzen zu entwickeln.“ Aber das Team arbeitet bereits an weiteren Zielstrukturen. Der Schwerpunkt liegt hierbei auf Angriffspunkten, die eine spezifische Abtötung der Erreger erlauben, oder deren Manipulation die Empfindlichkeit gegenüber klassischen Antibiotika wiederherstellt.
Das Paper wurde vor kurzem von dem Post-Publikations-Peer-Review-Service F1000Prime empfohlen und als „exceptional“ eingestuft.
Anbieter














